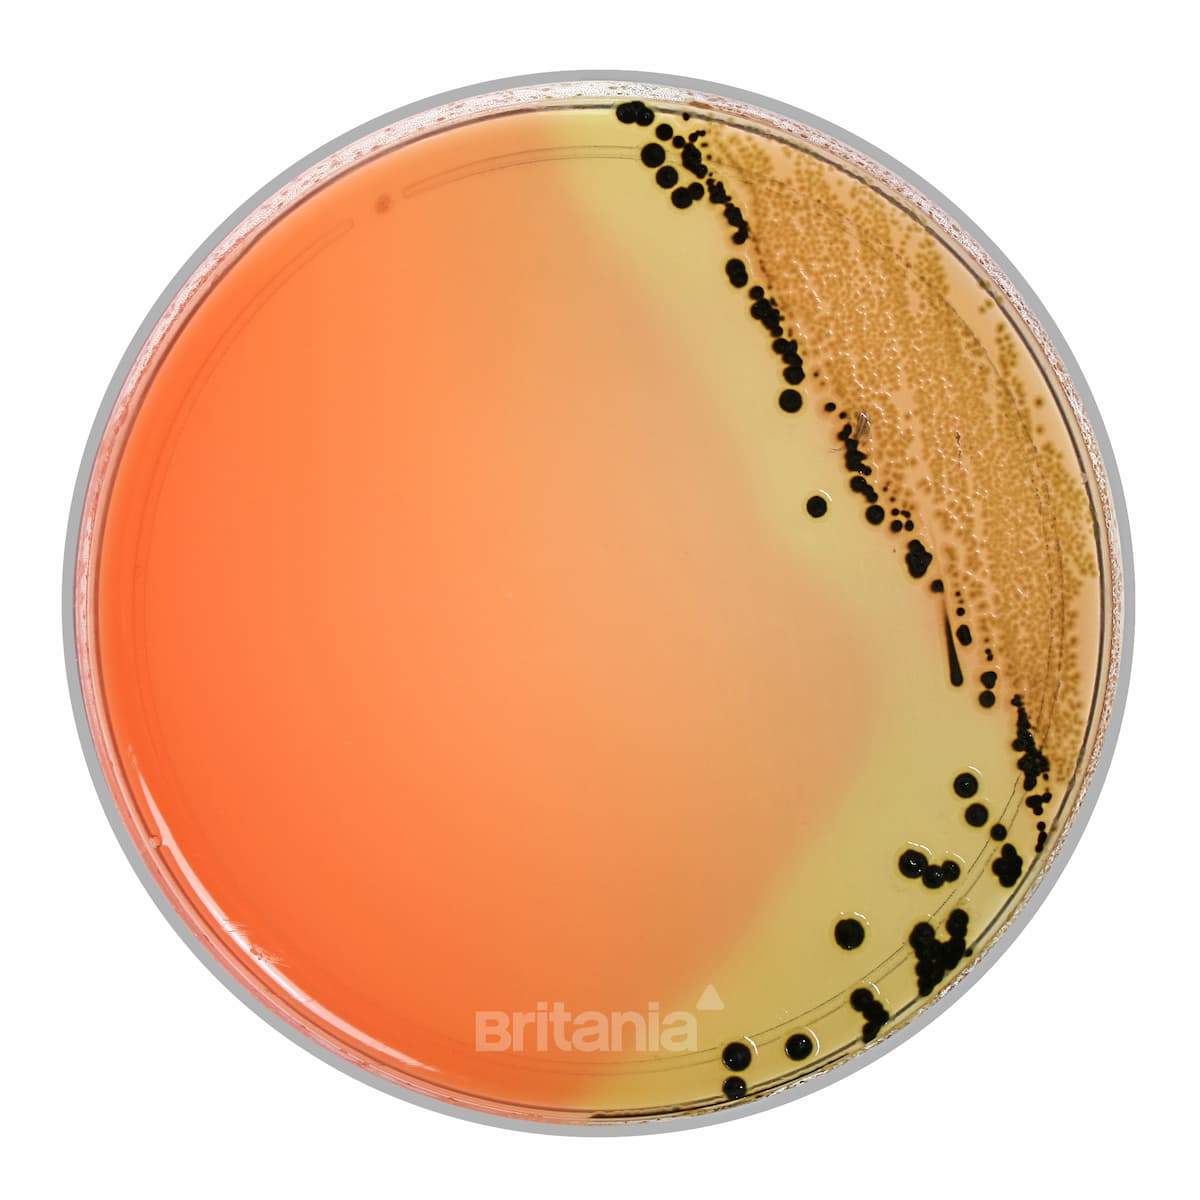
Hektoen Enterico Agar

Productos
- Medios de Cultivo
- Ingredientes y Suplementos
- Medios de transporte
- Hemocultivos
- Pruebas de sensibilidad
- Identificación bioquímica
- Material descartable
- Equipos de laboratorio
- Sistemas de extracción de sangre
- Hisopos y aplicadores
- Colorantes y decolorantes
- Indicadores biológicos
- Indicadores químicos
- Indicadores de limpieza
- Bioprocesos moleculares
- Quimica clinica
- Soluciones avanzadas
- Gradientes de concentración
- Alimentos y bebidas
- Inocuidad alimentaria
- Manejo de liquidos
- Cultivo celular
- Biologia molecular
- Quimica clinica avanzada
- Cromatografia
- Material descartable lab
- Medios de cultivo deshidratados
- Medios de cultivo listos para usar en frascos
- Medios de cultivo listos para usar en tubos
- Medios de cultivo listos para usar en placas
- Medios de cultivo selectivos en kits
- Ingredientes para medios de cultivo
- Suplementos para medios de cultivo
- Medios de transporte listos para usar
- Medios de transporte deshidratados
- Hemocultivos manuales
- Hemocultivos automatizados
- Equipos de hemocultivo
- Discos para antibiograma en viales
- Discos para antibiograma en cartuchos
- Multidiscos para antibiograma
- Pruebas de resistencia en kits
- Dispensadores para cartuchos
- Discos de diferenciación
- Reactivos para química clínica
- Reactivos reveladores
- Ansas y agujas de inoculación
- Espátulas de drigalski
- Pipetas Pasteur
- Placas de Petri
- Tips para pipetas
- Bolsas para autoclave
- Tubos cónicos
- Frascos recolectores
- Kits de calibración
- Conservación de cepas
- Plantillas para muestreo
- Densitómetros
- Tubos de extracción de sangre al vacío
- Tubos de extracción de sangre capilar
- Agujas
- Accesorios para extracción de sangre
- Hisopos con medios de transporte
- Hisopos flocados
- Hisopos secos
- Hisopos para monitoreo ambiental
- Soluciones concentradas en ampollas
- Soluciones concentradas en frascos
- Colorantes listos para usar
- Decolorantes listos para usar
- Ampollas autocontenidas
- Autocontenidos
- Incubadoras
- Medios de cultivo
- Tiras de esporas
- Cintas autoadhesivas
- Etiquetas autoadhesivas
- Integradores y emuladores
- Pruebas de Bowie & Dick
- Tiras químicas
- Indicadores de lavado
- Control ATP
- Termodesinfección